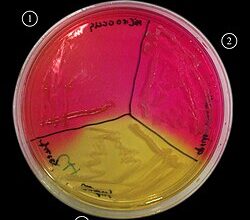
Шляхи передавання Staphylococcus aureus: як інфекція поширюється й передається

- До чого сниться чоловік дружині?
- Сни: мандри у власній підсвідомості
- Зустріч з коханцем
- Чоловік і сон: різні сценарії
- Сни з чоловіком: можливі значення
- Веселий і щасливий чоловік
- Сварка чи скандал
- Як розглядати сни, де фігурує чоловік? Локальні запити
- Регіональні акценти
- Як впоратися з потоком снів?
- Кілька порад:
- Що, якщо нічого не зрозуміло?
До чого сниться чоловік дружині?
До чого сниться чоловік дружині? От й дійсно, часто дивні сни підкидає нам наша підсвідомість. Ну от днями приснився чоловік… Що це може означати? Чи несе це приховані знаки або попередження? Давайте розбиратися!
Сни: мандри у власній підсвідомості
Сни — це наче той невидимий місток між реальним світом і нашим внутрішнім я. Вони розкривають таємниці, страхи, бажання, історії, які ми забули або і насправді не переживали. Іноді вони безглузді, іноді — пророчі. А коли мова йде про сни з образом чоловіка, зачаровують вони чи лякають? Що там за приховані значення?
Зустріч з коханцем
- Любов і комфорт: Він у сні — як символ затишку, захисту, чогось знайомого.
- Проблеми і конфлікти: Такий сон може свідчити й про приховані проблеми в стосунках.
- Бажання розвитку: Можливо, є бажання розвивати стосунки, більше поспілкуватися.
Чоловік і сон: різні сценарії
Сни про чоловіка можуть бути різноманітними — от сидить він удома, неначе Лев Толстой, або весь заклопотаний вирішує робочі питання. Як то розшифрувати? Покопаємо?
Сни з чоловіком: можливі значення
Веселий і щасливий чоловік
Чоловік, якого бачимо сміючимся уві сні, може бути символом радості, успіху чи навіть нового початку. Можливо, він зараз переживає найкращий період у своєму житті, або ж це передвістя радісних змін для вашої сім’ї. Та все ж — не все так просто.
Сварка чи скандал
Такий сон — неначе дзвіночок, що вказує на якісь неузгодженості чи непорозуміння, і може навіть приховану образу. Час іноді переглянути стосунки, можливо, і в дійсності забути про якісь старі образи. Бо ж кожен знає, що кращий спосіб вирішити проблему — обговорити її, а не закривати очі та вухаб.
Як розглядати сни, де фігурує чоловік? Локальні запити
Іноді у таких снах проскакують райони, містечка, які мають для нас значення. Мабуть, то такі собі підказки від підсвідомості? Київ? Одеса? Львів? Чим для тебе є ці міста? Може, в минулому була прямо історія любові чи сварок, пов’язаних з цими місцями? Запитай себе!
Регіональні акценти
- Львів: вказує на тонке сплетення культури і красивих стосунків.
- Київ: можливо, це символ великого життя чи ділових інтересів.
- Одеса: тут — привіт, пригоди! Що було там — любов чи конфлікт?
Як впоратися з потоком снів?
Всі ми це мали — безліч снів, розмиті спогади. Чи варто постійно їх аналізувати? Агов, є часи, коли просто хочеться забути і не їздити по одному й тому ж. Але якщо сон нав’язливо повторюється — можна спробувати розкрити його значення.
Кілька порад:
- Записуй сни: маючи під рукою блокнот, легше відстежити шаблони.
- Релакс: сядь, випий чаю і подумай про сновидіння, не напружуючись.
- Розмовляйте з чоловіком: обговорення таких снів може розкрити неочікувані речі.
Що, якщо нічого не зрозуміло?
Ой, та й справді, деколи сни залишаються загадкою. Іноді, як кажуть, нейрохірург би не допоміг 😉 То, може, воно й на краще? Не напружуйтеся, нехай ваші ночі залишаються приємно загадковими.